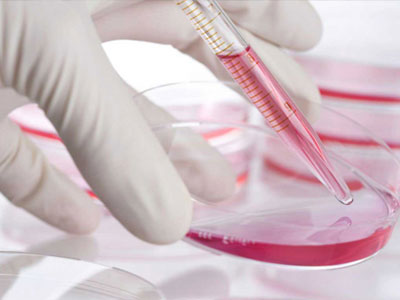
Νέο τεστ για τον καρκίνο του εντέρου

Ένα νέο μη επεμβατικό τεστ ανιχνεύει σε ποσοστό 92% τον καρκίνο του εντέρου.Είναι η πρώτη φορά που ένα τεστ, το οποίο δεν είναι επεμβατικό όπως η κολονοσκόπηση, εμφανίζει τέτοια ποσοστά αποτελεσματικότητας. Η νέα μέθοδος, που δεν έχει ακόμη εγκριθεί από την αρμόδια Αρχή Τροφίμων και Φαρμάκων (FDA) των ΗΠΑ, μπορεί να βελτιώσει κατά πολύ τις δυνατότητες εντοπισμού του καρκίνου του εντέρου και μάλιστα με φιλικό τρόπο, χωρίς τις «φασαρίες» της κολονοσόπησης, αφού οι ασθενείς αρκεί να συλλέξουν το σχετικό δείγμα στο σπίτι τους και να το πάνε για ανάλυση.
Αντίθετα με τα υπάρχοντα τεστ που βασίζονται αποκλειστικά στην ανίχνευση αίματος στα κόπρανα, το νέο τεστ με την χαρακτηριστική ονομασία “Cologuard” – «Φύλακας του εντέρου», ανιχνεύει αίμα όσο και ανώμαλο DNA, που απελευθερώνουν οι πολύποδες και οι όγκοι του εντέρου και το οποίο καταλήγει στα κόπρανα.
Το τεστ αναπτύχθηκε από την εταιρία Exact Sciences (που έχει τη σχετική εμπορική πατέντα) και την Κλινική Mayo. Η σχετική επιτυχής κλινική δοκιμή του σε περίπου 10.000 ανθρώπους ηλικίας 50 έως 85 ετών (χωρίς συμπτώματα καρκίνου), σε 90 αμερικανικά και καναδικά νοσοκομεία, έγινε από ερευνητική ομάδα με επικεφαλής τον καθηγητή Τόμας Ιμπεριάλε της Ιατρικής Σχολής του Πανεπιστημίου της Ινδιάνα, που έκανε και τη σχετική δημοσίευση στο ιατρικό περιοδικό “New England Journal of Medicine”.
Αν και η κολονοσκόπηση θεωρείται η πιο αποτελεσματική μέθοδος ελέγχου του εντέρου για τυχόν ύποπτους πολύποδες ή άλλους όγκους, σχεδόν οι μισοί άνθρωποι την αποφεύγουν. Από την άλλη, τα παραδοσιακά ανοσοχημικά τεστ κοπράνων, εκτός του ότι επίσης δεν είναι πολύ δημοφιλή (από τη φύση τους), εμφανίζουν πολλά παραπλανητικά αποτελέσματα (διαγνώσεις τόσο θετικές, όσο και αρνητικές, που είναι λάθος), καθώς κάθε αίμα που υπάρχει στα κόπρανα, δεν προέρχεται κατ’ ανάγκη από πολύποδα ή καρκίνο. Από την άλλη, δεν αιμορραγούν όλοι οι καρκίνοι του εντέρου σε βαθμό που να είναι ανιχνεύσιμοι.
Το νέο τεστ, καθώς είναι και γενετικό, έρχεται να καλύψει όλα τα παραπάνω κενά με μη επεμβατικό τρόπο. Το “Cologuard” εντόπισε το 92,3% των καρκίνων έναντι 73,8% του συμβατικού τεστ κοπράνων. Επίσης το νέο τεστ ανίχνευσε σχεδόν το 70% των προχωρημένων προκαρκινικών αλλοιώσεων στο έντερο έναντι 45% του παραδοσιακού τεστ (πρόκειται συνήθως για προκαρκινικούς πολύποδες μήκους μεγαλύτερου των δύο εκατοστών και για όσους εμφανίζουν υψηλού βαθμού δυσπλασία).
Το νέο τεστ μπορεί να αξιοποιηθεί και ως ενδιάμεσος διαγνωστικός έλεγχος ανάμεσα σε δύο κολονοσκοπήσεις, ώστε υπάρχει αξιόπιστη ένδειξη αν η επόμενη κολονοσκόπηση πρέπει να επισπευστεί. Προς το παρόν, το τεστ είναι διαθέσιμο μόνο για ερευνητικούς σκοπούς και δεν πωλείται.
Ο καρκίνος του εντέρου είναι η δεύτερη συχνότερη αιτία θανάτου από καρκίνο. Θεωρείται ο δυνητικά πιο θεραπεύσιμος καρκίνος, παρόλα αυτά στην πράξη ίσως είναι ο λιγότερο θεραπευμένος.
Περίπου εννέα στους δέκα ανθρώπους άνω των 50 ετών αντιμετωπίζουν κίνδυνο να εμφανίσουν καρκίνο του εντέρου, γι’ αυτό οι γιατροί συστήνουν από αυτή την ηλικία να πραγματοποιηθεί μία πρώτη κολονοσκόπηση, καθώς -αν αυτή γίνει σωστά- μπορεί να αποκαλύψει τυχόν προκαρκινικούς πολύποδες ή αφανείς όγκους σε εξέλιξη. Τουλάχιστον το 60% των θανάτων από καρκίνο του εντέρου θα μπορούσαν να αποφευχθούν, αν όλοι οι άνθρωποι άνω των 50 ετών έκαναν κολονοσκόπηση.
Περίπου το 90% των ασθενών με καρκίνο του εντέρου ζουν τουλάχιστον πέντε παραπάνω χρόνια, αν η νόσος τους διαγνωστεί στο αρχικό στάδιό της. Γι’ αυτό, έχει κρίσιμη σημασία να εντοπιστούν και να αφαιρεθούν έγκαιρα οι επικίνδυνοι προκαρκινικοί πολύποδες στη διάρκεια της κολονοσκόπησης.